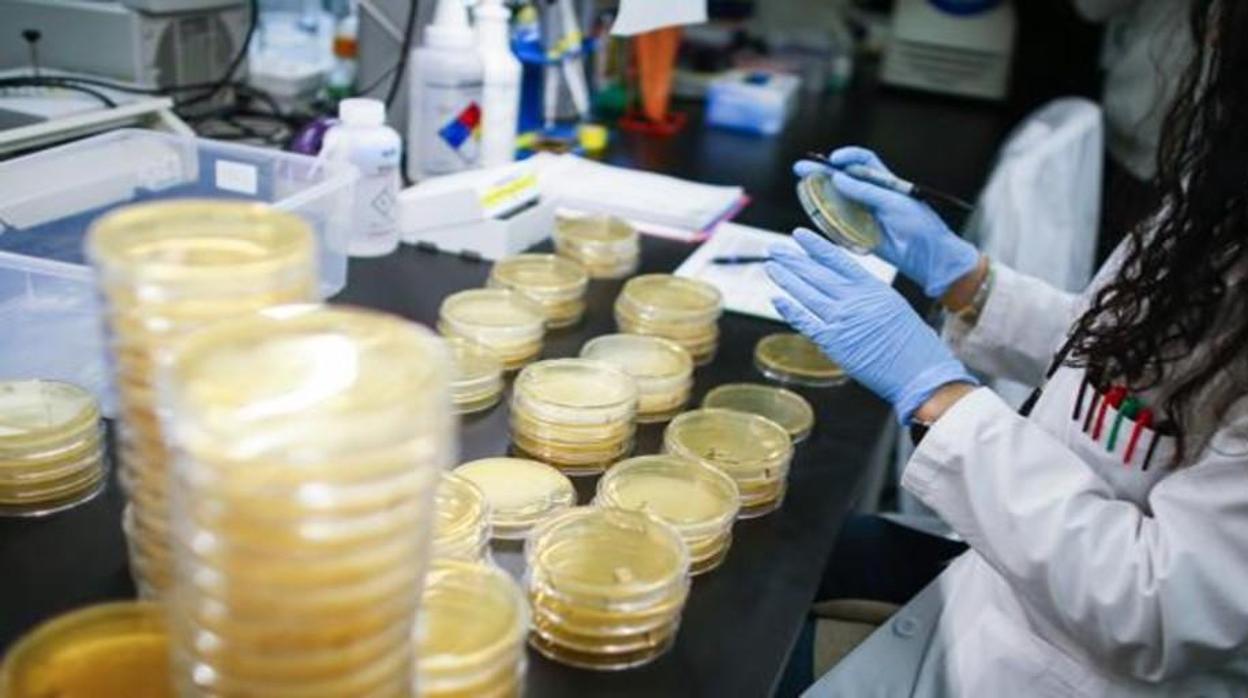
Laboratorio de análisis

Coronavirus en Andalucía: Doce nuevos casos elevan a 73 los infectados
Diez de ellos se han registrado en Málaga, que sigue siendo el mayor foco de Andalucía
S. A./ M. M.
Ya son 73 los casos confirmados por coronavirus en Andalucía , segun han confirmado este martes desde la Consejería de Salud y Familias. Según los responsables de dicho departamento, en las últimas horas se han detectado 12 nuevos afectados, diez de ellos en ... Málaga , provincia que sigue siendo el mayor foco de infección dentro de Andalucía. A primera hora de la tarde se ha confirmado un positivo en Córdoba , con lo que ya serían 73 los casos en la comunidad.
Esos diez casos malagueños son una mujer de 87 años y un hombre de 27. En ambos casos habían tenido contacto con personas que habían dado positivo anteriormente «y que se encuentran en seguimiento activo, según dictaminan los protocolos de Ministerio», explican en Salud.
También se han confirmado los casos de cuatro hombres de 16, 25, 44 y 51 años y de dos mujeres de 30 y 74 años que no han dicho haber estado en contacto con otros casos positivos ni viajes sospechosos. Como cinco de esos casos presentan síntomas de neumonía, están ingresados en los hospitales malagueños Virgen de la Victoria, Regional, Costa del Sol y Antequera. El otro caso está en seguimiento activo, pero no ingresado.
Además de esos casos hay otros dos positivos -una mujer de 44 años y un hombre de 19- que han viajado a Italia y que no han sido ingresados sino que se encuentran «en seguimiento activo».
En Jaén también se ha confirmado un nuevo caso. Se trata de un hombre de 59 años con neumonía que no habría tenido contacto con personas con coronavirus ni viajado a zonas de riesgo. Está ingresado en el hospital Universitario de Jaén. En Sevilla está el último caso. Es una mujer de 27 años bajo seguimiento activo pero no ingresada.
Todos estos nuevos positivos, advierten desde la Consejería, «están pendientes de confirmación del Centro Nacional de Microbiología . De momento, se han activado los protocolos de prevención dictaminados por el Ministerio de Sanidad para determinar los posibles contactos directos que hayan tenido estos pacientes. Por su parte, el resto de casos decretados en Andalucía, «no refieren cambios».
Visitas a centros sanitarios
Por otro lado, desde el comité de seguimiento del coronavirus han acordado la restricción de acceso a los centros sanitarios andaluces . Así, «se ha decidido restringir las visitas a los centros hospitalarios de los Informadores Técnicos Sanitarios, limitar los acompañantes de quienes se acerquen a los servicios de urgencias para contener el avance de la epidemia, así como de los pacientes hospitalizados, de forma que cada paciente sólo podrá tener un acompañante», han explicado desde la Consejería de Salud.
Esta funcionalidad es sólo para suscriptores
Suscribete
Esta funcionalidad es sólo para registrados
Iniciar sesiónEsta funcionalidad es sólo para suscriptores
Suscribete